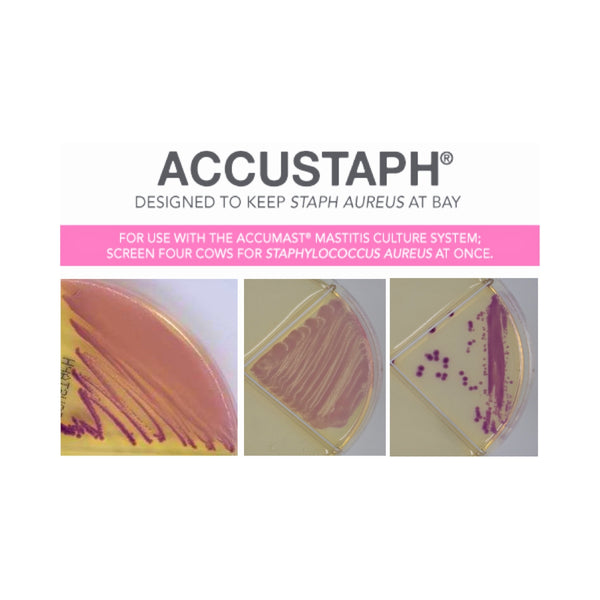

Additional Information
Global Gold Standard for Staph Aureus Identification
Join the growing wave of farms using AccuStaph - the incredibly accurate, cost-effective tool to detect the contagious cows that have the costliest form of mastitis, and in some cases, even eradicating it from their herds all together.